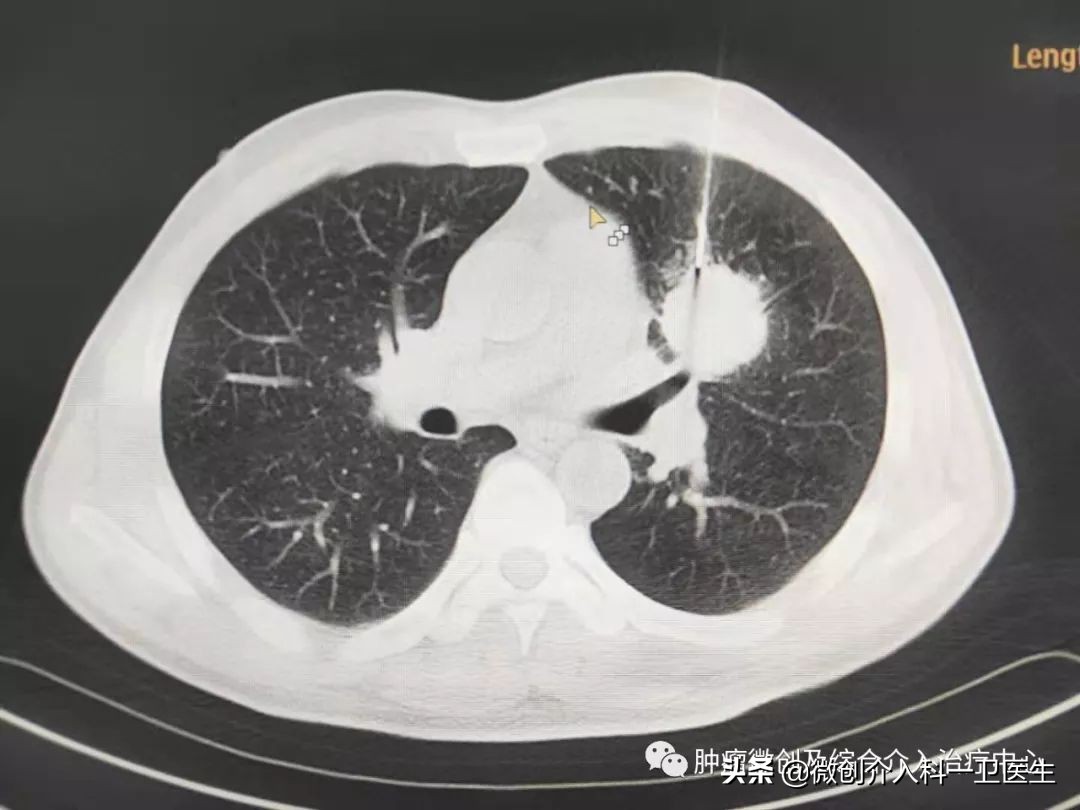
运城市第一医院肿瘤手术,运城市第一医院微创介入手术

运城市第一医院肿瘤微创及综合介入科
特色技术——肿瘤的穿刺活检术
技术简介:
1. 肿瘤是严重危害人类健康及生命的疾病,近年来发病率逐渐上升,且发病年龄逐渐下降,早期发现、正确的诊断、及时治疗对预后有重要的影响。随着检查手段及方法的不断提高,使诊断的正确率逐渐提高,但仍有很大一部分肿瘤不具备典型的影像学特点,诊断困难。正确的诊断需要临床、影像及病理三结合。其中,病理诊断对治疗方案的选择起着关键作用。穿刺活检是获取病理诊断的主要途径


图1、2 局麻后在CT精确引导下经穿刺活检针穿刺进入肿瘤内部,创口约棉签样大小,取出长条形软组织,进行病理化验。

图 3. CT引导下穿刺过程。

图4、5、6. 引导下精准穿刺进入肿瘤内部穿刺图

图7、 穿刺完病理结果,等待肿瘤微创治疗。
进行活检前我们建议应遵循以下重要原则:
1. 活检前应象制定手术方案一样高度重视,周密计划。因为这是肿瘤治疗的开始,是至关重要的第一步,不正确的活检会给患者带来灾难性的后果。
2. 应严格遵守无菌操作原则,像常规手术一样进行皮肤准备,止血缝合。
3. 确保活检不影响以后手术方案的制定,活检污染区应能被完整切除。
4. 确保有足够的有代表性的组织标本供病理医生诊断,如病理医生不能明确诊断,应及时提供详细的临床及影像检查资料。
5. 如果医生或医院不具备诊治肿瘤的条件,应在活检前将肿瘤患者转到具备诊断及治疗肿瘤的医生或医院那里接受正规的治疗。

CT引导下经皮肺穿刺活检在肺部占位性病变诊断中的诊断价值 - 中国知网
http://kns.cnki.net/kcms/detail/detail.aspx?dbcode=CJFD&filename=YXYY201920140&dbname=CJFDTEMP


运城市第一医院
肿瘤微创及综合介入治疗中心
科 室 简 介
运城市第一医院开展介入诊疗技术始于2008年, 2017年12月正式成立隶属于临床医学的肿瘤微创及综合介入科,设立独立的专业门诊和病房,是运城市首家独立最大的介入治疗专业科室。自创建以来,在科主任李辉教授带领下,本着高起点、严要求的标准,在广泛开展血管内及非血管性介入治疗的基础上积极拓展各项新业务、新技术,开展了大量高、新、难的手术项目。经过数年的发展,科室人员不仅在数量上明显壮大,而且在人才质量上也有了显著提高,现拥有专业医生8人,博士1人,硕士研究生两人,主任医师2人,副主任医师1人,主治医师2人 住院医师3人,多人有过外出进修学习经历。目前设有48张标准床位,设在住院部楼13楼东,拥有3台运城地区最先进的现代化DSA机(大C臂),1个血管介入和肿瘤微创导管室及一个兼做外科和介入的复合手术室。1个CT引导下介入手术室。
并在山西省率先开展了动脉药盒的植入,运城地区率先开展了肿瘤射频/微波消融术,碘125粒子植入术。
技术力量 全科拥有强大合作北京微创介入医师团队和省内外各大医院微创介入团队技术支持。(卫生部北京医院、北京友谊医院、北京*013院医**、北京302医院、北京304医院、北京307医院、北京大学肿瘤医院、北京朝阳医院、河南省人民医院、郑大二附院、西京医院、唐都医院)专家人数14名,其中主任医师12 名、副主任医师2 名。
本科特色
开展介入诊疗范围:
1、急诊介入:肝破裂、脾破裂、骨盆骨折大出血、产后大出血、咯血、消化道出血。
2、肿瘤介入:原发性肝癌、胃癌、胰腺癌、肺癌、食道癌、肠癌、胆道梗阻等各种恶性肿瘤。肝脏巨大血管瘤、子宫肌瘤等良性肿瘤。
3、血管介入:布加综合征、肾动脉狭窄。
4、非血管途径介入:穿刺活检术、放射性碘125粒子植入、射频/微波消融、食管支架、手术后吻合口狭窄支架、胆道支架、输卵管狭窄再通、肝肾囊肿、等。
特色诊疗:
恶性肿瘤方面:
1、肺癌的微创介入治疗
(肺占位穿刺活检定性、肿瘤供血动脉血管介入栓塞术、肿瘤放射性碘125粒子植入术、肺癌射频消融术、肺癌骨转移疼痛的介入治疗、肺癌咯血的介入治疗)
2、肝癌的微创介入治疗
(肝占位穿刺活检定性、肿瘤供血动脉血管介入栓塞术、肝癌门脉癌栓形成放射性碘125粒子植入术、肝癌射频消融术、肝癌转移的疼痛介入治疗)
3、各种原因梗阻性黄疸的介入治疗(胆管癌、胰腺癌、壶腹部占位等)
(经皮肝穿刺黄疸的介入引流,梗阻部位局部支架的微创介入治疗、肿瘤供血动脉靶向化疗药物灌注的介入治疗)
4、胰腺癌的微创介入治疗
(胰腺占位的穿刺活检定性、胰腺癌疼痛介入治疗、胰腺癌放射性碘125粒子植入术,胰腺癌导致黄疸介入治疗、胰腺癌肝转移局部动脉灌注介入治疗)
5、食管癌的微创介入治疗
(食管癌供血动脉局部动脉药物灌注介入治疗、食管癌(不能吃饭患者)普通支架植入治疗、食管癌载药(碘125粒子)支架植入治疗)
6、不能手术的结直肠癌的微创介入治疗
(结直肠癌局部动脉靶向化疗药物灌注降期可能将不能手术的降期为可手术病人、介入栓塞堵住的肿瘤供血血管,让肿瘤快速萎缩坏死)
7、不能手术的贲门胃底癌的微创介入治疗
(贲门癌供血动脉靶向化疗药物灌注降期可能将不能手术的降期为可手术病人、改善患者饮食问题)
8、肾癌的微创介入治疗
(肿瘤供血动脉血管介入栓塞术、肿瘤放射性碘125粒子植入术、肾癌射频消融术、肺癌骨转移疼痛的介入治疗)
9、输尿管肿瘤的微创介入治疗(肾积水)
(经皮肾穿刺输尿管双G管置入,输尿管局部支架植入术)
10、膀胱癌的微创介入治疗(尤其是反复血尿)
(肿瘤供血动脉血管介入栓塞术、堵住肿瘤血管达到治疗目的)
11、不能手术前列腺肿瘤等的微创介入治疗
(肿瘤供血动脉血管介入栓塞术、堵住肿瘤血管达到治疗目的)
12、不能手术的宫颈癌、卵巢癌的微创介入治疗
(结直肠癌局部动脉靶向化疗药物灌注降期可能将不能手术的降期为可手术病人、介入栓塞堵住的肿瘤供血血管,让肿瘤快速萎缩坏死)
13、放疗后食管狭窄、十二指肠狭窄的微创介入治疗
(放疗后6个月内,局部放入空肠营养管,改善患者营养问题,6个月后局部支架植入术,患者可经口进食)
14、肿瘤引起的气道狭窄的微创介入治疗
(气道狭窄局部支架植入术)
15、各种肿瘤切除术后,动脉化疗药物灌注,避免手术部位肿瘤复发。
16、CT引导下肿瘤穿刺活检术。一根细针帮你判定是否为肿瘤,判定是什么类型的肿瘤,决定治疗方案。
17、各种原因骨转移瘤疼痛介入治疗、碘125粒子植入术、骨水泥填充术。
肿瘤供血动脉化疗药物灌注(高浓度化疗药物杀灭肿瘤,全身无副反应、几乎不会掉头发)
良性肿瘤及其他疾病方面:
1、肝血管瘤的微创介入治疗
(良性肝血管瘤供血动脉局部介入栓塞,避免外科手术、肝血管瘤局部射频消融术)
2、子宫肌瘤、子宫腺肌症的微创介入治疗
(良性子宫肌瘤及腺肌症供血动脉局部介入栓塞,避免外科切除子宫、让肌瘤及腺肌症萎缩缺血坏死)
3、脾功能亢进的微创介入治疗(白细胞、红细胞、血小板减低)
(脾动脉部分栓塞术微创介入治疗)
4、难治性腹水的介入治疗
(经皮颈静脉穿刺门-体静脉分流术)
5、前列腺增生的微创介入治疗
(双侧前列腺动脉介入栓塞术、堵住增生前列腺动脉,让前列腺萎缩、达到治疗目的)
6、高血压(肾动脉狭窄引起的高血压)
(肾动脉支架植入术)
7、布-加综合征
(狭窄静脉球囊扩张术+必要时支架植入术)
各种出血方面:
1、咯血的介入治疗
(支气管扩张大咯血介入治疗,堵住出血动脉达到治疗目的)
2、呕血的介入治疗(门脉高压引起的食管胃底静脉曲张)
(经皮颈静脉穿刺门-体静脉分流术)
3、便血的介入治疗
(出血血管介入栓塞、堵住出血动脉达到治疗目的)
4、尿血的介入治疗
(出血血管介入栓塞、堵住出血动脉达到治疗目的)
5、外伤引起的各种脏器出血。避免切除器官(肝、脾脏、肾脏)
(出血血管介入栓塞、堵住出血动脉达到治疗目的)
6、不明原因妇产科出血
(凶险性前置性胎盘术中腹主动脉球囊阻断术、瘢痕妊娠刮宫前介入栓塞避免大出血)
7、各种原因术后大出血的微创介入治疗
(出血血管介入栓塞、堵住出血动脉达到治疗目的)

门诊地址:肿瘤微创及综合介入科门诊4楼东三排
住院地址:第一医院住院大楼13楼东
0359-2355131
0359-2355132
孙惠英科主任:17735929955
卫毅楠副主任:17735928522
13593588552(微信同号)
黄江河副主任:17735928388
运城市第一医院肿瘤微创及综合科介入科
咨询预约电话
17735928522

扫一扫关注
广 而 告 之

▶ 运城市第一医院——运城人家门口的大医院
▶ 全国35所知名三甲医院160余名专家教授坐诊
▶ 来院就诊,地上、地下停车场免费停车
▶ 门诊提供全程优质服务,住院有单间和特需病房
医院地址:运城市人民北路最北端(12、26路公交车可直达)
咨询电话 ☎ :0359-2355900(门诊办)

运城市第一医院
助力健康中国
提升百姓幸福生活品质
